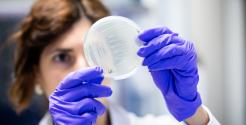

La Toulouse Biotech Alley pousse les murs
15 000 m2, 420 chercheurs, 110 publications scientifiques par an… La Toulouse Biotech Alley, située au sein du campus de l'INSA Toulouse, à Rangueil, abrite trois structures complémentaires jouant chacune un rôle distinct dans le processus de montée en maturité des projets de biotechnologies : Toulouse Biotechnology Institute (TBI), Toulouse White Biotechnology (TWB) et Critt Bio-Industries. Une « allée » qui va s’enrichir d’ici à mi-2027 d’un nouveau bâtiment de 3 600 m2, la Halle des biotechnologies. Porté par l’INSA Toulouse, il abritera à la fois les nouveaux locaux du Critt Bio-Industries, des équipes de la société Carbios et un plateau de 900 m2 alloué à TWB, ce qui lui permettra de doubler sa surface d’accueil de start-up. Dans ce contexte, quid de l’hypothèse de la création d’un véhicule juridique commun aux trois structures constituant la Toulouse Biotech Alley ?, s’interroge La Lettre M. « Nous travaillons sur cette possibilité mais le plus important est de bâtir une feuille de route commune », répond Pascal Chapon.